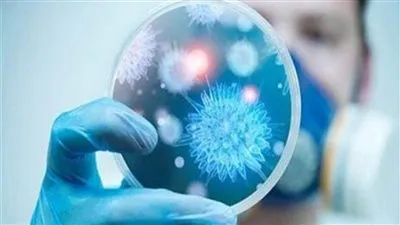
هل تنتهي جائحة كورونا؟

عاجل
نسور قرطاج أمام اختبار لا يقبل الخطأ.. تفاصيل مواجهة تونس وتنزانيا الحاسمة في كأس أمم إفريقيا 2025
صراع التأهل يشتعل في المغرب.. كل ما تريد معرفته عن مباراة تونس وتنزانيا في كأس أمم إفريقيا 2025
بث مباشر مباراة تونس وتنزانيا في كأس أمم إفريقيا 2025.. القنوات الناقلة وموعد اللقاء وطرق المشاهدة أونلاين
🔥 مواجهة الحسم في كأس عاصمة مصر.. الأهلي يواجه المقاولون العرب في قمة الإثارة
الأهلي يواجه المقاولون العرب.. معركة حاسمة في كأس عاصمة مصر